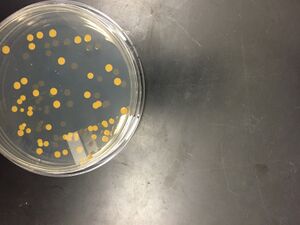

User:Moriah M. Mitchell/Notebook/Biology 210 at AU
Thursday, March 10, 2016 Food Web Entry Purpose: The purpose of the experiment was to identify relationships between organisms found in Transect Five.
• Data collected from previous experiments was used to draw conclusions about the interaction of organisms in transect five.
• A food web was constructed based on these conclusions.
Figure 1. Food Web constructed from organisms found in Transect Five.
Specific species of bacteria could not be included because the PCR product of soil bacteria from Transect Five was not sequenced. Specific protists that fit into this food web are Difflugia, Pandorina, Eurglena, Paramecium, Colpidium, and Pelomyxa. Their were not included in the image of the food web because they would not have fit.
Conclusions and Future Directions:
Organisms living in the transect are dependent on one another. In general, more complex organisms in the transect obtain energy from less complex organisms.
MMM
Thursday, February 25, 2016
16s Sequence Analysis
Purpose: The purpose of the experiment was to determine the species of the soil bacteria collected from Transect 5 using the sequence if base pairs for the 16S rRna gene. Based on the results of gram-staining and observed cell morphology, we hypothesized that the bacteria sequenced would be a rod-shaped gram-positive species.
• The 16S sequence of bacteria collected from the soil in Transect 5 was amplified by PCR and sent to a lab for sequencing.
• The sequence of nucleotides obtained from the lab was entered into BLAST ® in order to identify the species of the bacteria.
Figure 1. Gel from Microbiology lab. Our PCR product failed to produce bands on the gel.
Because our PCR product failed to produce bands on the gel, it was not sequenced. This is a sequence of base pairs for bacteria obtained from our transect in Spring 2015.
Raw Sequence: NNNNNNNNGGNNGCNANANTGCAGTCGAGCGAATGGNNTGATANCTTGCTCTCNNAANTTAGCGGCGGACGGGTGATTAA TACNTGGGTAACCGGCCGNGGGACTGNCATAACTCCGGGAAACCTGGTATAATACCGGATAANATTTTGAACTGCNGGGT TCGAAATTGCTTGGCCGCTTCNGCTGTCCCTTATGGATGGACCCACNTCGCATTATCTAGTTGGTGANGTAACAGCTCAC CAANGTAACCATGCGTANCCGACCTGANANGGTGATCGGCCACACTGGGACTGANCCACGGNCCAGACTCCTAGGGGAAG CANCANTANGGAATCTTCCCCTGTGGACGAAAGTCTGACGGAGCAACGCCNCGTGTNTGATGAANGCTTTCTNGTCGTAA AACTCTGTTGTTATGGATNAACAAGTGCTAGTTTAATAAGCTGGCACCTTGNNANNACCTNCCCNNAAAGCCGCGGCTAA CTACGTGCTANCAGCCNTGGNAATANNTNTGTGGCAAACTGTATGCCGANTTNTCGCNCGTAANANGGCGTCCCCCGTTT CTTACCTCTGATGGGAACNNNNGGNGNATNTCTNGAGANGTGCANNGNAAAGGGTAANATGNGAGCNA
BLAST ® identified this sequence as belonging to Bacillus cereus. The alignment scores were very high.
Conclusions and Future Directions:
Bacillus cereus is a rod-shaped gram-positive bacterial species typically associated with food poisoning and more dangerous cases of gastrointestinal infections in humans(Bottone). It is a motile species and is commonly found in soil (Bottone). Although the rRNA sequenced was not from the same colonies we gram stained and observed under the microscope, it is possible that both were B. cereus because the bacteria we observed were rod-shaped and gram-positive. We were not able to observe motion in our bacteria, but that is because we had trouble seeing them at all on our wet mount slide.
Bottone, E. J. (2010). Bacillus cereus, a volatile human pathogen. Clinical microbiology reviews, 23(2), 382-398.
MMM
Thursday, February 18, 2016
Exercise VI -Embryology and Development
Purpose: The purpose of this experiment is to determine the effect of caffeine on zebrafish morphology, size, and development. Based on previous research, we hypothesized that zebrafish exposed to caffeine would develop to be shorter in length than zebrafish not exposed to caffeine.
• Add 2mL of deerpark water to each of 24 wells in two twelve well plates for the control group.
• Add 2mL of 40mg/L caffeine solution to each of 24 wells on two twelve well plates for the experimental group.
• Use a pipette to place one fertilized zebrafish embryo in each well in both the experimental and control plates.
• Clean the wells on days 2 (Friday) and 5(Monday) and 6(Tuesday) and 7(Wednesday) by pipetting out dirty solution and replacing it with new deerpark water for the control group and new (40mg/L) caffeine solution for the experimental group.
• Observe the fish using a dissection microscope on days 2,5,6, and 7. and record observations.
• Feed the fish daily beginning on day 5.
Figure 1. Zebrafish exposed to caffeine on day 7
Figure 2. Control Zebrafish on day 7
Table 1. Results
| Day | Tasks Performed | Control Group Observations | Experimental Group Observations |
|---|---|---|---|
| 1 | Embryos staged | Embryos appear to be healthy | Embryos appear to be normal |
| 2 | Solution cleaned, embryos observed | Embryos appear to be healthy | Embryos do not appear to be noticeably different from control embryos |
| 5 | Fish fed and observed | Fish appear to be healthy | Fish do not appear to be noticeably different from control embryos |
| 6 | Fish fed | Fish appear to be normal | Fish appear to move slower than control fish. |
| 7 | Fish fed and observed | Many of the embryos appear to be dead. | Many of the embryos appear to be dead. The experimental fish move slower than the control fish. |
Conclusions and Future Directions:
Zebrafish in both the control and experimental group have died. Noticeable differences in movement between the experimental and control have become apparent. Fish exposed to caffeine appear to move slower which may indicate that exposure to caffeine has affected their neuromuscular development. We will continue to care for the living zebrafish them by feeding them and cleaning their solution and continue to observe their development. We will measure the zebrafish to determine whether differences in length between the control and experimental group exist.
MMM
Thursday, February 11, 2016 Exercise V -Vertebrates and Invertebrates
Purpose: The purpose of this experiment was to characterize the invertebrates in transect five collected using a Berlese Funnel. We hypothesized that many different types of invertebrates would be found in our transect.
• Separate the Berlese Funnel from the conical flask containing ethanol.
• Pour the top 10-15 mL of ethanol into a petri dish.
• Pour the rest of the liquid into another petri dish.
• Examine invertebrates in the petri dish using a dissection microscope.
• Identify the class of each specimen using a dichotomous key.
No invertebrates were found in the liquid collected from our Berlese Funnel, so we analyzed invertebrates from another group's funnel.
Table 1. Invertebrates
| Organism (Phylum and Class) | Length in mm | Number in Sample | Description of organism |
|---|---|---|---|
| Phylum: Arthropoda
Class: Insecta Order: Protura |
1.5 | 1 | antenna, 3 legs, tail, segmented body |
| Phylum: Mollusca | 2 | 2 | 4-6 legs, shell structure, feelers |
| Phylum: Mollusca | 2 | 2 | 4-6 legs, shell structure, feelers |
| Phylum: Platyhelminthe | 2.5 | 2 | flat, not segmented |
| Phylum: Arthropoda
Class: Insecta Order: Protura |
3 | 1 | antenna, 3 legs, tail, segmented body |
Figure 1. Organism #1 under dissection microscope. Phylum: Arthropoda Class: Insecta Order: Protura
Figures 3. Top to bottom: Organism#2, Organism #3, and Organism #4 under dissection microscope.
Figure 3. Organism #5 under dissection microscope. Phylum: Arthropoda Class: Insecta Order: Protura
Table 2. Possible Vertebrates in Transect
| Common Name | Phylum | Class | Order | Family | Genus | Species | Abiotic characteristics that would benefit species | Biotic characteristics that would benefit species |
|---|---|---|---|---|---|---|---|---|
| Squirrel | Chordata | Mammalia | Rodentia | Sciuridae | Sciurus | Sciurus carolinensis | They could use the mulch to hide | Squirrels could eat the plants |
| Rat | Chordata | Mammalia | Rodentia | Muridae | Rattus | Rattus norvegicus | Rats could food in the mulch | Rats could eat the plants |
| Rabbit | Chordata | Mammalia | Lagomorpha | Leporidae | Sylvilagus | Sylvilagus floridanus | The rabbits could take shelter in the planters | Rabbits could eat the plants |
| Robin | Chordata | Aves | Passeriformes | Turdidae | Turdus | Turdus migratorius | The birds could use dead plants to build nests | Robins could eat insects and worms in the transect |
| Blue Jay | Chordata | Aves | Passeriformes | Corvidae | Cyanocitta | Cyanocitta cristata | The birds could use dead plants to build nests | Robins could eat insects and worms in the transect |
Conclusions and Future Directions:
We found organisms between 1.5 and 3mm in length. Both the smallest and largest organisms were arthropods and appeared to be the same type of arthropod. The two invertebrates found in the top sample appeared to be the same species and two of the invertebrates found in the bottom sample appeared to be the same species. The two samples from the Berlese Funnel were different from one another.
Figure 4. Possible Food Web for Transect #5
MMM
Thursday, February 4, 2016 Exercise IV -Plantae and Fungi
Purpose: The purpose of this experiment was to characterize the plants found and prepare a Berlese Funnelto collect invertebrates to analyze next week. We hypothesized that tmost of the plants in our transect would be dicots.
• Collect samples of five different plants from the transect and record the location they were retrieved from.
• Collect about twenty dead leaves and a small amount of the soil covering them.
• Measure the height of each plant sample and observe the vascularization.
• Observe a cross section of each plant sample under a dissection microscope.
• Load 10 microliters of dye and 15 microliters of PCR product from the bacteria cultured from the hay infusion in agarose gel and run the gel for twenty minutes.
• Observe bands on gel.
• Observe black bread mold under a dissecting microscope.
• Prepare a Berlese Funnel by placing a screen in the bottom of a funnel and filling it with dead leaves from the transect. Then parafilm and tape the funnel into a 50mL conical tube containing 25mL 50:50 ethanol/water. Secure the apparatus to a rind stand and place under a 40 watt lamp. Cover with tin foil.
Figures 1-3. Right to left: Plant #1, Plant #2, and Plant #3 under dissection microscope.
Figures 4-5. Right to left: Plant #4, Plant #5 under dissection microscope.
Table 1. Characteristics of Plants Collected from Transect #5
| Transect Sample Plants | Location and # in Transect | Description (size and shape) | Vacularization | Specialized Structures | Mechanisms of Reproduction |
|---|---|---|---|---|---|
| #1 | Ground plant near the edge of the transect | Ovular 18cm | netlike veins | stomata | seeds |
| #2 | In the soil of the corn planter | 32 cm linear | parallel veins | stomata | seeds |
| #3 | In the soil of the onion planter | 7 cm ovular | netlike veins | stomata | seeds |
| #4 | Plant in the soil of an unmarked planter | 4.5 cm ovular | netlike veins | stomata | seeds |
| #5 | Leaf found on the ground | 14 cm spade | netlike veins | stomata | seeds |
No seeds were collected from our transect. None of the plants we collected had flowers.
Figures 6. Black bread mold under dissection microscope.
Fungi sporangia are the part of fungi that produce spores (Freeman et. al.,2014). They are important because fungi reproduce through spores. Black bread mold is a zygomycete. You can tell that it is a fungus because it has mycelia.
Figures 7. Gel from PCR product of hay infusion culture.
No bands were observed on the gel in the lane our sample was loaded in.
Conclusions and Future Directions:
Based on the vascularization of the plants we collected, we believe that Plant #1, Plant #3, Plant#4, and Plant #5 are dicots while Plant #2 is a monocot. All five plants were tracheophytes. This supports our hypothesis that our transect would contain more dicots than monocots. We were not able to identify most of the plants, but we believe that plant #2 belongs to the genus Zea.
Because no bands were observed on the gel in the lane our sample was loaded in, we cannot draw any conclusions as to which bacterial species was cultured. This was probably due to an error.
Next week, we will observe the invertebrates collected using Berlese Funnel in order to continue characterizing life in our transect.
Freeman, S., Allison, L., Black, M., Podgorski, G., Quillin, K., Monroe, J., & Taylor, E. (2014). Biological science (5th ed.). Boston, MA: Pearson.
MMM
Thursday, January 28, 2016
Exercise III - Microbiology and Identifying Bacteria
Purpose: The purpose of this experiment was to characterize the colonies and cells of bacterial species found in Transect Five. We hypothesized that the change in smell and appearance of the Hay Infusion Culture may have occurred because microorganisms in the culture metabolized nutrients present in the culture. We also hypothesized that the bacteria found on the nutrient agar plates would be different that the bacteria observed on the nutrient agar plates with tetracycline. We predicted that Archaea species would not be found on the agar plates from the Hay Infusion because Archaea tend to grow in extreme environments and neither Transect Five nor the agar plates are extreme environments.
1) Observe the Hay Infusion Culture and record any changes in appearance or color.
2) Observe colony morphology on agar plates and record number of colonies on each plate.
3) Prepare a wet mount of one colony from each of four plates:10^-3 dilution of Hay Infusion Culture on nutrient agar plate, 10^-3 dilution of Hay Infusion Culture on nutrient agar plate with tetracycline, 10^-5 dilution of Hay Infusion Culture on nutrient agar plate, and 10^-5 dilution of Hay Infusion Culture on nutrient agar plate with tetracycline.
a)For each slide, collect a small amount of growth from the agar surface with a sterilized loop.
b) Mix it with a drop of water on the slide.
c) Cover with a cover slip.
4) Gram Stain one sample from each of four plates:10^-3 dilution of Hay Infusion Culture on nutrient agar plate, 10^-3 dilution of Hay Infusion Culture on nutrient agar plate with tetracycline, 10^-5 dilution of Hay Infusion Culture on nutrient agar plate, and 10^-5 dilution of Hay Infusion Culture on nutrient agar plate with tetracycline.
a) For each slide, collect a small amount of growth from the agar surface with a sterilized loop and mix it with a drop of water on the slide.
b) Heat fix the sample to the slide by briefly holding it over a flame.
c) Cover the heat fixed sample with crystal violet for one minute,
d) Rinse with water.
e) Cover with Gram’s iodine mordant for one minute.
f) Rinse with water.
g) Decolorize with 95% alcohol for fifteen seconds.
h) Rinse with water.
i) Cover with safranin stain for thirty seconds.
j) Rinse with water.
k) Observe cell morphology and staining using microscope. 5) Set up PCR for 16S Amplification of bacteria from , 10^-5 dilution of Hay Infusion Culture on nutrient agar plate, and 10^-5 dilution of Hay Infusion Culture on nutrient agar plate with tetracycline.
a) Add 25 microliters of primer/water to mixture to each of two PCR tubes and flick tubes until PCR beads are dissolved.
b) Pick up a small amount of bacteria from the nutrient agar plate without tetracycline using a sterile toothpick and swirl in one PCR tube for five seconds. Replace cap of PCR tube.
c) Pick up a small amount of bacteria from the nutrient agar plate with tetracycline using a new sterile toothpick and swirl in the other PCR tube for five seconds. Replace cap of PCR tube.
d) Place PCR tubes in PCR machine.
The odor of the Hay Infusion Culture was far milder than it was the previous week. There was no longer a distinct film at the surface of the liquid. There was still a layer of sediment at the bottom of the jar.
Figure 1. Nutrient agar plates. Left: 10^-3 dilution of Hay Infusion Culture. Right: 10^-5 dilution of Hay Infusion Culture.
Figure 2. 10^-3 dilution of Hay Infusion Culture on nutrient agar plate with tetracycline.
Figure 3. 10^-5 dilution of Hay Infusion Culture on nutrient agar plate with tetracycline.
Figure 4. 10^-7 dilution of Hay Infusion Culture on nutrient agar plate with tetracycline.
Colonies did not form on the nutrient agar plates plated with 10^-7 and 10^-9 dilutions of the Hay Infusion Culture. Colonies did not form on the nutrient agar plate with tetracycline plated with the 10^-9 dilution of the Hay Infusion Culture. The colonies on the nutrient agar plates looked the same as the colonies on the nutrient agar with tetracycline plates, however there were slightly fewer colonies on the nutrient agar with tetracycline plates.
We were unable to observe any movement of bacterial cells on the wet mount slides observed under the microscope.
Figure 5. Wet mount of colony from 10^-3 dilution of Hay infusion Culture on nutrient agar.
Figure 6. Wet mount of colony from 10^-3 dilution of Hay infusion Culture on nutrient agar with tetracycline.
We could not find cells on the wet mount slides of the 10^-5 dilutions of the Hay Infusion Culture.
Table 1: 100-fold Serial Dilutions Results
| Dilution | Agar Type | # of Colonies on Plate | Conversion Factor | Colonies/mL |
|---|---|---|---|---|
| 10^-3 | Nutrient | 1100 | 10^3 | 11000 |
| 10^-5 | Nutrient | 85 | 10^5 | 850 |
| 10^-7 | Nutrient | 0 | 10^7 | 0 |
| 10^-9 | Nutrient | 0 | 10^9 | 0 |
| 10^-3 | Nutrient + tet | 1000 | 10^3 | 10000 |
| 10^-5 | Nutrient + tet | 51 | 10^5 | 510 |
| 10^-7 | Nutrient + tet | 1 | 10^7 | 10 |
| 10^-9 | Nutrient + tet | 0 | 10^9 | 0 |
Figure 7. Gram stained colony from 10^-3 dilution of Hay infusion Culture on nutrient agar under 40x objective lens.
Figure 8. Gram stained colony from 10^-5 dilution of Hay infusion Culture on nutrient agar under 40x objective lens.
Figure 9. Gram stained colony from 10^-3 dilution of Hay infusion Culture on nutrient agar with tetracycline under 40x objective lens.
Figure 10. Gram stained colony from 10^-5 dilution of Hay infusion Culture on nutrient agar with tetracycline under 40x objective lens.
Table 2. Bacteria Characterization
| Colony Label | Plate Type | Colony Description | Cell Description | Gram + or Gram - |
|---|---|---|---|---|
| 10^-3 N | Nutrient | Yellow, round, smooth, about 0.5 millimeter diameter | Spherical | - |
| 10^-5 N | Nutrient | Yellow, round, smooth, about 2-3 millimeter diameter | Rod | - |
| 10^-3 T | Nutrient + tet | Yellow, round, smooth, about 0.5 millimeter diameter | Spiral | - |
| 10^-5 T | Nutrient + tet | Yellow, round, smooth, about 0.5 millimeter diameter | Spherical | + |
Conclusions and Future Directions:
Tetracycline acts by inhibiting bacterial growth rather than killing existing bacterial cells (Tetracycline, 2016). It accomplishes this by binding to the bacterial cell's ribosome and impeding the cell's ability to synthesize proteins (Thaker, Spanogiannopoulos, & Wright, 2010). Tetracycline is used to inhibit the growth of both gram-negative and gram-positive bacterial species including Vibrio cholerae , Rickettsia, Chlamydiae , Brucella, and Francisella tularensis (Tetracycline, 2016).Because the difference in colony count between the nutrient agar plates and nutrient agar plates with tetracycline was not significant, the bacteria on the plates is likely resistant to or not susceptible to tetracycline.
Although we have not yet identified the bacterial species present in our transect, our hypothesis that different bacterial species be observed on the nutrient agar plates than on the nutrient agar plates with tetracycline does seem to be supported. Although the colony color, size, and morphology of the nutrient agar plates seemed to be the same as those of the nutrient agar plates with tetracycline, the bacteria looked very different from one another under the microscope. Sperical and rod-shaped gram-negative bacterial species were observed on the nutrient agar plates, while a spiral shaped gram-negative species and a round-shaped gram-positive species were observed on the nutrient agar plates with tetracycline.
Next week, we will run the PCR products of one one bacterial colony from the nutrient agar plate and one bacterial colony from the nutrient agar plate with tetracycline in order to determine the identity of the bacterial species present.
Tetracycline. (2016). In Encyclopaedia Britannica. (3 Feb. 2016) Retrieved from http://academic.eb.com/EBchecked/topic/588969/tetracycline
Thaker, M., Spanogiannopoulos, P., & Wright, G. D. (2010). The tetracycline resistome. Cellular and molecular life sciences, 67(3), 419-431.
MMM
Thursday, January 21, 2016 Exercise II - Identifying Algae and Protists
Purpose: The purpose of this experiment was to identify the protists and algae found in Transect 5. We hypothesized that the different niches observed in out Hay Infusion Culture would contain different protists and algae because each niche has different abiotic and biotic components.
• Observe the Hay Infusion Culture and record characteristics including appearance and odor.
• Identify and describe each distinct niche observed in the Hay Infusion Culture.
• Observe a sample from each niche using a microscope to locate algae and protists.
• Measure organisms and use a dichotomous key to identify them.
• Mix hay infusion culture by swirling jar with lid on.
• Inoculate 10mL sterile broth with 100 microliters of hay infusion culture and swirl to mix to create 10-2 dilution.
• Inoculate 10mL sterile broth with 100 microliters of the 10-2 dilution and swirl to mix to create 10-4 dilution.
• Inoculate 10mL sterile broth with 100 microliters of the 10-4 dilution and swirl to mix to create 10-6 dilution.
• Inoculate 10mL sterile broth with 100 microliters of the 10-6 dilution and swirl to mix to create 10-8 dilution.
• Spread 100 microliters of each dilution onto separate nutrient agar plates.
• Spread 100 microliters of each dilution onto separate nutrient agar plus tetracycline plates.
• Incubate plates at room temperature for one week.
Figure 1 Diagram of serial dilution procedure.
Observations and Data: The Hay Infusion Culture smelled foul and of decomposing plant matter. It had three distinct layers. The top layer was filmy and medium brown in color. There were several brown twig-like structures in the top layer. The middle layer was very cloudy a slight yellow tint. A distinct line marked separation between the middle and bottom layers. The bottom layer was darker and tinted yellow-brown. Sediment was visible in the bottom layer.
Figure 2. Hay Infusion Culture. Three distinct niches: top, middle, and bottom are observed.
Figure 3. Aerial view of top layer of Hay Infusion Culture.
Organisms Observed:
Figure 4. Organisms found in top niche. Difflugia left and Pandorina, round just above center. These organism were difficult to photograph.
Difflugia: The organism was light brown in color and oblong in shape with a point at one end. Shapes were observable within the organism. It was motile but moved very slowly. It was 150 micrometers in length. Difflugia is a protist.
Pandorina: The organism was light green in color and round in shape. It appeared to be made of 8 cells and had flagellar movement. It measured 40 micrometers in diameter. The organism is a type of green algae and performs photosynthesis.
Figure 5. Drawing of Euglena in middle niche. The organism moved before we could take a picture of it.
Euglena: The single cell organism was green in color and long in shape in shape with a point at one end. It measured 75 micrometers in length and moved quickly. The organism is an intermediate between an algae and a protist because it is a mixtroph.
Figure 6. Paramecium found in middle niche.
Paramecium: The unicellular protist was light green in color and measured 30 micrometers in length. It was oblong in shape and moved very quickly. Cilia were visible.
Figure 7 .Drawing of Colpidium found in middle niche.
Colpidium: The unicellular protist was light green in color and measured 50 micrometers in length. It was oblong in shape and used cillia to move.
Figure 8. Pelomyxa found in bottom niche.
Pelomyxa: The organism was almost colorless and nearly round in shape. It measured approximately 500 micrometers in diameter. Vacuoles were visible within the cell. Pelomyxa is a protist and uses flagella to move.
Conclusions and Future Directions: Because different types of protists and algae were found in the three distinct niches of the hay infusion, our hypothesis was supported. Next week the cultures prepared using the serial dilutions will be observed in order to identify the bacterial species living in the transect.
How Paramecium meets all of the needs of life: Paramecium are protists so they acquire energy by consuming nutrients from their environment. They use energy to move and reproduce. Paramecium are made up of a single cell. Paramecium store information in two nuclei, the macronucleus and the micronucleus. Paramecium reproduce both by binary fission and conjugation. Paramecium is a member of the Aveolata lineage, so it has involved over time.
If the Hay Infusion "grew" for another two months, I predict that fewer protists would be present because the jar contains a limited amount of nutrients and protists need to consume nutrients to survive. As the amount of nutrients present in the jar dwindled, competition among protists for resources would increase. Selective pressure would favor organisms that absorb nutrients more efficiently or do not expend as much energy and thus require fewer nutrients to survive. If the jar was kept in a sunlit area with sufficient CO2, I would not expect algae to survive better than protists because they would still have access to what is needed to perform photosynthesis.
MMM
Thursday, January 14, 2016 Exercise I - Examining Biological Life at AU
Purpose: The purpose of this experiment was to gather qualitative information about Transect Five and make a hay infusion culture from a sample of the transect’s soil and organic material in order to begin understanding the abiotic and biotic components that make up the ecosystem within the transect. We hypothesize that the Hay Infusion Culture will yield a diverse array of protists because the transect contains many different niches which could support a wide range of species. [[ Materials and Methods:]]
• Observe the transect. Record the location, topography, and general characteristics of the transect.
• Draw and aerial-view diagram of the transect that includes all of its important biotic and abiotic features.
• Record all of the abiotic and biotic components of the transect and note their location.
• Collect a representative sample of soil and ground plant matter from the transect.
• Combine 10.0 grams of the transect sample with 500.0 mL of deerpark water and 0.1 grams dried milk in a jar.
• Mix the contents of the jar for ten seconds by shaking the jar with the lid on before removing the lid and allowing the jar to sit for one week.
Observations and Data: The transect was located at the American University Community Garden. The transect was relatively flat and level but contained six raised wooden planters. The planters contained dark soil and wilted plants. A hose was stretched from the southeast portion of the transect to the to the southwest portion of the transect. The surface of the transect was primarily composed of soil, mulch, and dead leaves. A wire-mesh fence bordered the transect at the southeast and southwest edges. A golf ball was found on the on the ground approximately two meters northwest of the gate. It was approximately 6 pm at the time of sample collection. The sky was clear and it was approximately two degrees Celsius.
Biotic components: plant material in planters, bacteria and microorganisms in soil, leaves, wood making up planters (because it was once living) , Abiotic components: fence, soil, hose, gate, golf ball
Figure 1: Aerial view of Transect Five
Figure 2: Photograph of southwest portion of Transect 5. Carrot planter, Onion Planter, Herbs Planter, and Broccoli Planter
Figure 3: Photograph of central to northeast corner of Transect 5. Unlabeled planters 1 and 2 containing unidentified plant matter are on the left side of the photograph. The hose is pictured at the bottom of the photo. Planters at the right side and top of the photograph were not within the boundaries of the transect.
Conclusions and Future Directions: The ecosystem within the transect is made of many abiotic and biotic components. No conclusion can be drawn at this time as to whether or not the transect contains many types of protists because the Hay Infusion Culture will not be observed until next week. At that time, samples from the Hay Infusion Culture will be observed using a microscope in order to describe and identify protists and algae present in the sample.
M.M.